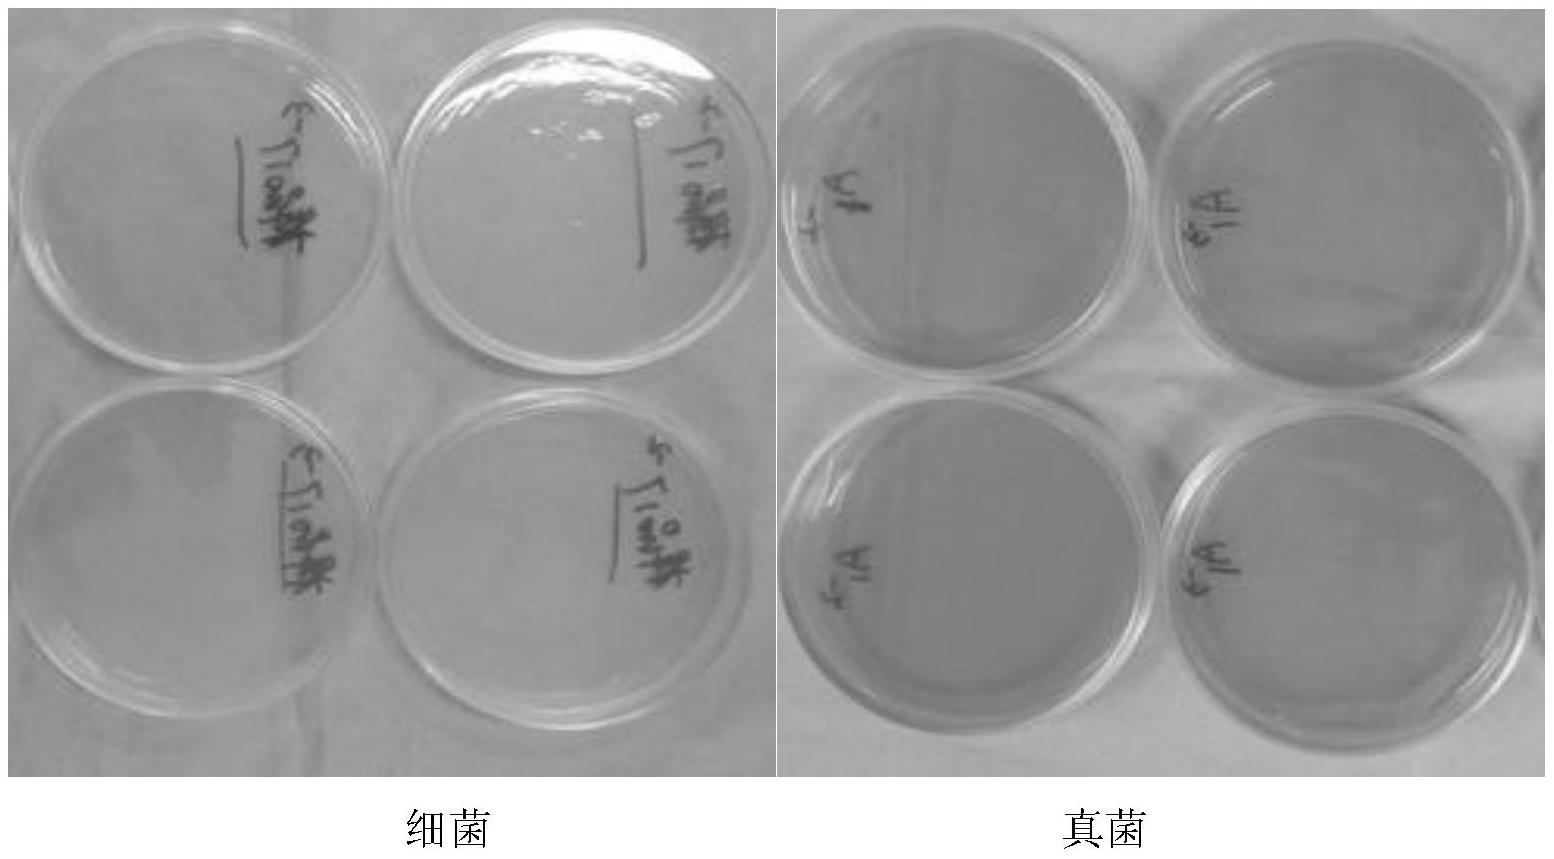

授权公布号:CN106667797B
具有自防腐功能的温和洗发水组合物
有效
申请
2016-12-30
申请公布
2017-05-17
授权
2019-11-15
预估到期
2036-12-30
| 申请号 | CN201611257619.6 |
| 申请日 | 2016-12-30 |
| 申请公布号 | CN106667797A |
| 申请公布日 | 2017-05-17 |
| 授权公布号 | CN106667797B |
| 授权公告日 | 2019-11-15 |
| 分类号 | A61K8/891;A61K8/34;A61K8/365;A61K8/37;A61K8/44;A61K8/46;A61Q5/02 |
| 分类 | 医学或兽医学;卫生学; |
| 申请人名称 | 广东丹姿集团有限公司 |
| 申请人地址 | 广东省广州市花都区花东镇先科二路23 |
专利法律状态
2021-02-05
专利申请权、专利权的转移
状态信息
专利权的转移;IPC(主分类):A61K8/891;专利号:ZL2016112576196;登记生效日:20210126;变更事项:专利权人;变更前权利人:广州市科能化妆品科研有限公司;变更后权利人:广州市科能化妆品科研有限公司;变更事项:地址;变更前权利人:510800 广东省广州市花都区花东镇先科二路23号;变更后权利人:510800 广东省广州市花都区花东镇先科二路23;变更事项:专利权人;变更前权利人:广州市白云联佳精细化工厂 广东丹姿集团有限公司;变更后权利人:广东丹姿集团有限公司
2019-11-15
发明专利权授予
状态信息
授权
2017-06-09
实质审查的生效
状态信息
实质审查的生效;IPC(主分类):A61K8/891;申请日:20161230
2017-05-17
发明专利申请公布
状态信息
公布
摘要
本发明属于日用化工领域,涉及一种具有自防腐功能的温和洗发水组合物。本发明所述的一种自防腐功能的温和洗发水组合物,包含如下重量百分数的组分:氨基酸类表面活性剂,5.0~50%;辅助表面活性剂,0.5~50%;调理剂0.05~5.0%;螯合剂,0.01~0.5%;辛甘醇和戊二醇,0.1~5.0%;其余为含水载体。本发明组合物具有清洁调理头发的功能,同时具有自防腐效果,不添加防腐剂,温和低刺激。